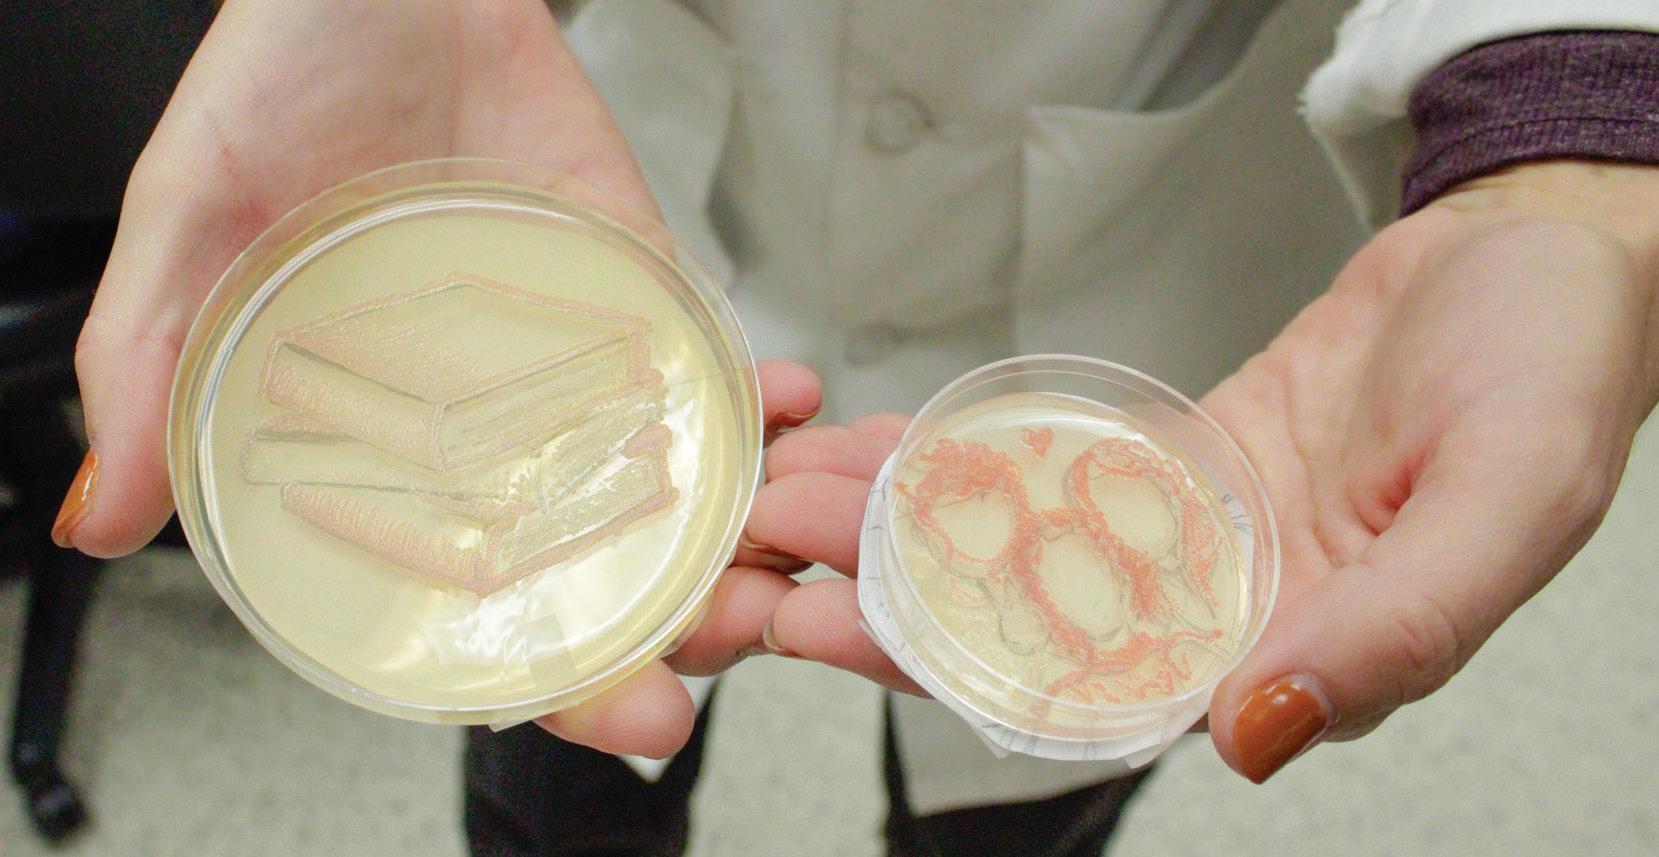

Judging Justice
Forum creates dialogue between MI judges, GV legal studies students

GV Theater’s “Romeo and Juliet” breathes new life into Shakespearean classic
GV cross country earns over 25 personal records at Joe Piane Notre Dame Invite

![]()
Forum creates dialogue between MI judges, GV legal studies students

GV Theater’s “Romeo and Juliet” breathes new life into Shakespearean classic
GV cross country earns over 25 personal records at Joe Piane Notre Dame Invite

BY JOSEPH POULOS LANTHORNEDITORIAL@GVSU.EDU
With the U.S. Drug Enforcement Administration moving towards reclassifying marijuana from a Schedule I to a Schedule III drug, conversations about the substance have been sparked among many, including college students.
Reclassifying marijuana would not legalize the drug for recreational purposes nationwide. Instead, marijuana would become a controlled substance similar to ketamine or acetaminophen-codeine combinations. These Schedule III drugs can be prescribed medically, but also have serious federal criminal repercussions to anyone who traffics the drugs without permission. Currently a Schedule I drug, marijuana sits alongside other drugs in the category, such heroin, LSD and ecstasy. The reclassification would allow for significant advancements in research
surrounding marijuana. Instead of scientists relying on reports from cannabis users, formal clinical studies could administer the drug to subjects. This could open the door for scientists to answer decades-long questions and myths surrounding marijuana.
Like any large political movement, there are opponents to the reclassification of marijuana. Those opposed are concerned the reclassification would create further confusion regarding the drug’s legality, as marijuana would still remain federally illegal. Others support the removal of marijuana from the list of controlled substances, similar to that of alcohol and tobacco. Substances that have been taken off the list are still federally regulated, but done so in different ways.
Michigan, one of 24 states in America, passed landmark legislation in 2018 that legalized recreational marijuana usage for those over 21. Although it has been legalized in Michigan, it is illegal
to use or possess marijuana on federal property. This includes federally funded college campuses like Grand Valley State University.
“If the government can still regulate (cannabis) like they do alcohol, I don’t really see the point in making it a controlled substance, especially if people can still be put in jail for it,” said GVSU senior Max Klumper.
GVSU senior Oliver Geroux agrees with Klumper, and feels the reclassification would not make a large difference if marijuana is still federally illegal.
“I understand making (cannabis) a less serious drug, but I feel like it’s kind of pointless to go through that whole process (reclassification of marijuana) if it would still be technically illegal,” said Geroux.
Alcohol and Other Drugs Services (AOD) at GVSU recently hosted a webinar designed to educate students on marijuana-related issues and the substance’s impacts. The presentation
focused largely on marijuana abuse, highlighting that cannabis is both physically and psychologically addictive.
According to AOD’s presentation, about 9% of cannabis users become addicted. Cannabis use disorder, an addiction to the substance, is characterized by increased tolerance, cravings and withdrawal symptoms. The disorder can disrupt a user’s daily life.
With the Nov. 5 election approaching, it is important that college students be familiar with cannabis-related policies on the ballot. Michigan voters will see several local marijuana policy proposals in November. Specific communities, including Pontiac, Caro, and Algonac, will be voting on regulations relating to cannabis businesses and grow licenses. These local initiatives are part of Michigan’s ongoing adjustments to cannabis regulations, although no statewide changes are being proposed.


At the Lanthorn, we strive to bring you the most accurate news possible. If we make a mistake, we want to make it right. If you find any errors in fact in the Lanthorn, let us know by calling 616-3312464 or by emailing editorial@lanthorn.com.
The Grand Valley Lanthorn is published biweekly by Grand Valley State University students 17 times a year. One copy of this newspaper is available free of charge to any member of the Grand Valley Community. For additional copies, at $1 each, please contact our business offices.
BY JOSEPH POULOS LANTHORNEDITORIAL@GVSU.EDU
Grand Valley State University has selected senior government attorney Jessica Karbowski Weare as the University’s next general counsel. Weare will begin her position at GVSU on Oct. 28, following the retirement of Patricia Smith, who spent 25 years working at GVSU.
Weare is an accomplished attorney who specializes in legal counsel for public service and other government positions. She is an alumni of Albion College, and earned her law degree from Yale University. She most recently served as the chief operating officer and chief legal counsel for the Michigan Department of Lifelong Education, Advancement and Potential.
Representing the state of Michigan, Weare has worked as deputy legal counsel to Gov. Gretchen Whitmer, and was the acting commissioner of the Michigan State Lottery. Throughout her work for state government, Weare advised on topics including economic development, education, civil rights and natural resources. She has also worked with Facebook as an associate general counsel.
Weare said she is looking forward to spending time in the role and becoming an important part of the University’s staff.
“As general counsel, I look forward to supporting the mission, vision and values of the University by helping the leadership, faculty, staff and students accomplish their goals,” Weare said. “I hope to become a trusted team member and strategic partner in a way that opens additional opportunities to provide timely and meaningful legal support across the institution.”
Weare said she hopes to offer a unique and helpful perspective in regards to legal advice for the University.
“I like helping people reach their goals, think creatively and solve problems,” Weare said. “Useful legal advice can help you reach your goals, while avoiding potential pitfalls that could otherwise trip you up.”

Weare said her main desire is to make a difference, no matter where she works.
”My career decisions have been largely motivated by the potential to make an impact,” Weare said. “I have spent the vast majority of my legal career in public service, in both state and federal government. This is because those government roles provided an ability to work on issues that impacted the world, the country and Michigan.”
Stating her career goal is to create change, Weare said she believes there is meaningful work being done at GVSU, which attracted her to the position.
“My decision to join the Grand Valley team is similarly driven by the impactful work happening at the University, and the opportunity to contribute to that work as general counsel,” Weare said. “It is hard to imagine a better way to continue investing in my home state than by working for an institution that is preparing the leaders of tomorrow to shape their communities.”
Weare’s past experiences have been diverse and varied. She said she has many memories from these positions which will only aid in her future work with GVSU.
“I have been incredibly fortunate to have a dynamic and interesting career as an attorney,” Weare said. “While it is impossible for me to pick a favorite position, there have been some remarkable moments across my career. For example, I will never forget speaking on behalf of the United States at international organizations, watching Governor Whitmer sign an executive order that I drafted or handing out my first big check as acting commissioner of the Michigan Lottery.”
Weare said she believes experience from her previous roles will serve her well, help her to succeed at GVSU and help others in the University community.
“There also have been smaller behind the scenes moments where I saw programs and initiatives that I worked on make a meaningful difference in someone’s life,” Weare said. “I am so excited to add to this list of memorable moments with the work we will do together at Grand Valley.”


BY MAX BUFKIN LANTHORNEDITORIAL@GVSU.EDU
An art creation event was hosted by the American Society for Clinical Laboratory Science (ASCLS) from Oct. 4-5 at Grand Valley State University, which allowed students to create artwork out of living microorganisms.
The ASCLS event was held at GVSU’s Cook-DeVos Center for Health Science. ASCLS invited students and organization members to create “agar art,” which is the practice of painting with microorganisms on a petri dish “canvas.” Agar is a gel compound that frequently is used to diagnose patients and create cultures of microorganisms. This marks the third year that ASCLS has hosted the workshop, which demonstrates to students the intersection of science and creativity.
The event was in partnership with Laker Lab Scientists, a GVSU student organization that provides students with “an outlet for community involvement and professional development” through various resources and activities.
Though the event took place in the GVSU Medical Laboratory Science (MLS) lab, it was open to all students regardless of major, which allowed
those who had no previous scientific experience to participate. ASCLS organizers offered guidance to the participants as they created their agar art pieces, providing tips and tricks along the way. After the agar artworks were completed, they were photographed and sent to the participants’ emails.
Participants were encouraged to submit their artwork to the American Society of Microbiology (ASM) for their 2024 agar art contest. The theme of this year’s contest centers around the question, “What brings you joy?”
According to Smithsonian magazine, agar powder (derived from seaweed) is mixed with sterilized water and nutrients to create a gelatinous substance. Scientists add microorganisms, such as fungi or bacteria, to the substance and observe their growth within the gel. Depending on the organisms implanted in the gel, agar will change colors, allowing a full palette of differing shades and hues. In scientific studies, agar is used to diagnose patients and test which microorganisms are present in their system. Scientists have been using agar to create art since the 1920s, but its popularity rose when the ASM hosted its first agar art contest in 2015.
Submissions for ASM’s agar art

contest will remain open until 11:59 p.m. on Oct. 27.
“I think there is an art to any profession if you look at it the right way,” said MLS faculty member Mattie Brechbiel. “By taking a field like microbiology and placing it in a fun and accessible space, we give everyone the opportunity to experience science in a way that appeals to them.”
The President of Laker Lab Scientists, Chloe Jones, hopes students in attendance were able to learn more about lab careers through the event.
“By doing this art workshop, it allows us to show the community a bit of what we do in the laboratory, and hopefully spark interest in others to pursue Medical Laboratory Science as a career,” Jones said.
Both Brechbiel and Jones expressed their excitement about how the art workshop informed students on MLS research. Brechbiel and Jones said medical work utilizing agar is typically overshadowed by other healthcare professions, and falls to the background of the field. One goal of the agar art workshop was to show students that agar work is not only fun, but also vital in diagnosing and treating patients.
“We do not have to always isolate topics into left brain and right brain spaces, creative and rigid,” Brechbiel said. “Yes, science requires specific rules to be followed for success, but so does baking. We can see art in any space if we approach it the right way.”

BY EVA ORTIZ LANTHORNEDITORIAL@GVSU.EDU
New vending machines have been installed at Grand Valley State University’s Mary Idema Pew Library and Fieldhouse Arena. Unlike other vending options on campus, the new machines named “Just Baked” offer a variety of hot meals that aim to provide a more filling and nutritious food option compared to typical vending machine snacks.
The Just Baked vending machine was brought to the library to accommodate students during long study sessions. As student schedules vary, the new machine is an attempt to fill the demand for accessible, round-the-clock dining options. The Just Baked machine is accessible to students and library patrons during all open hours, and provides more meal options for students while studying.
The new machine offers a number of hot meals like potstickers, mac and cheese and cheese-filled soft pretzels.
“The decision was based on feedback from students and staff requesting more food options, especially during late hours,” said Glen Behan, the food service director
for GVSU’s Laker Food Co. “The library is a central hub for studying, and we wanted to offer a way for students to access hot food without having to leave the building.”
Prior to the new installation, the only option for fresh food service at the library was the coffee and tea shop GV Brew. GV Brew primarily offers different beverage options and a small selection of light snacks, but has very specific and limited hours.
Some students expressed that previously, they didn’t eat in the library due to the lack of food options.
“I normally get the sushi from the dining area in Kindschi Hall, but I’ll try any food on campus,” said GVSU senior Ian Rant. “I normally don’t eat inside the library, but I like the idea of having food and snack options there so when I’m studying, I don’t have to leave my spot to find food.”
However, some students have questioned the quality of the vending machine’s meals, as a handful of the meals are made with perishable ingredients like meat and eggs. Since the machine is able to serve hot food, many students speculate the meals must be pre-made, and have questioned their freshness. Behan

said students shouldn’t worry because the food is properly managed and prepared in a made to order fashion. The new machine also sends real-time data to the machine’s supplier, Day One Vending, to allow for accurate and efficient restocking.
“The meals are sealed and stored in temperature-controlled compartments within the machine,” Behan said. “The machine uses smart technology to heat the meals to the ideal temperature when selected, ensuring freshness and optimal taste.”
Behan assured that each meal has
an expiration date that is followed strictly, and that food is removed from the machine prior to its expiration.
“Inventory is monitored closely to minimize food waste, (and we) adjust the supply based on consumption patterns,” Behan said.
According to Behan, more popular locations on10 campus are being considered for the addition of even more machines. GVSU’s Pew Campus downtown Grand Rapids is expecting to welcome three Just Baked machines in the near future.



BY MACENZIE CONN
I recently watched the new psychological horror film “Speak No Evil,” a remake of a Danish film with the same name released in 2022. The only difference was the fact that the main characters were American, and the remake had a more eventful ending. Despite this, the story was the same. It made me wonder, was it really worth a remake? The original had only been out for two years. I feel we are seeing this trend of remaking films for profit more and more in the
film industry, and it makes me angry.
I understand some of the reasons Hollywood is remaking old films. Many creators want to introduce old movies to new audiences. For example, the original “Planet of the Apes” was released in 1968. It was praised by critics and audiences alike, and won an Academy Award. The success of the movie led to four more films, comic books, merchandise and more. Why not introduce such a popular creation to a new generation? Based on the fact the 2001 remake grossed $68.5 million its debut weekend, it was just as successful the second time around.
However for the majority of films, I feel remakes are not necessary. Sure, many newer films have accomplished massive success, but are they not essentially ripoffs of the original? Hollywood shouldn’t just refer to old catalogs when they run out of ideas. I believe it limits creativity by providing a crutch.
Another reason behind remakes is the motivation to appeal to existing audiences. There is less financial risk involved for the filmmakers if they are creating a work that already has a fanbase. For example, if a producer
knows the original “Ghostbusters” was successful, why wouldn’t they attempt to remake it for a greater profit among a new generation? At the very least, fans of the original movie will be intrigued and want to see the remake, so the film will make money either way.
Some movies may be remade simply because they could technically be improved with new production equipment. For example, the original “Clash of the Titans” that was released in 1981 used stop-motion animation. Of course the 2010 remake appealed to a larger audience, as they didn’t have to suffer through a dated animation style. However, I think this takes away from the original experience. The technology that was used at the time the films were made speak to the era and vision that they were created in.
To spice up remakes, producers may make changes such as having the cast be completely female or adapting the pre-existing world of the film to today’s technology. This can appeal to new audiences in addition to its original fans. However, these slight changes are simply a safe play compared to coming up with a completely new movie idea.
Just because a movie replaces computers with cellphones and uses modern slang doesn’t mean it’s a creative endeavor. When creating fictional worlds, opportunities for world building are endless. Why rely on an idea from 30 years ago? Audiences love things that feel unique. That is what creates fandoms and lines that wrap around movie theaters on opening night, and the audience reaction to remakes is simply not the same. Instead of remakes, I think we need to see more films that match our own technology and speak to the time we live in. I hope to see films that can be watched years from now and take audiences back in time to when they were created. We need more of a push to make movies that we can introduce to our children, like our parents did to us. Films should feel like an accurate depiction of what our culture looks like. I don’t want to rewatch reiterations of the same film forever. We need original movies, and we won’t get them until Hollywood decides to take risks again and stop remaking films.

BY COLLIN ST. JOHN
The 2024 presidential race is coming to an end in just a few weeks and personally, I could not be more excited. I find myself counting down the days because no matter who wins, the campaign advertisements will finally come to an end. I feel that the 2024 presidential advertisements are invasive, ineffective and negatively polarizing. Their existence opens up a broader conversation about advertising in the media-- one that I feel brings out to the worst in people and their behavior during the weeks leading up to the presidential election.
These ads have taken over online media during the last couple of months.
You can’t go a few hours, or do much online without seeing Harris’ or Trump’s face. How many times have you been greeted by Kamala Harris or a 40-second Donald Trump ad before you go to stream your favorite shows or watch a video on YouTube? In classes, it’s even difficult for professors to use video demonstrations without a political ad popping up, which adds a slight sense of discomfort to the classroom.
The advertisements are loud, obnoxious, typically 30-50 seconds and oftentimes, unskippable. On apps like TikTok, Instagram or Facebook, they pop up every few scrolls. In my opinion, the media is already flooded with discussion about the election, so being constantly reminded of the candidates on what feels like every online platform seems a bit over the top.
Perhaps the worst part is that these advertisements are ineffective. The majority of them are based on attacking the other candidate rather than discussing their own campaign. Harris tends to gear her ads to the working class, describing Trump as an asset to the wealthy. Trump on the other hand, usually focuses on Harris’ immigration policies and depicts her time as vice president as a “failure.” Hardly any of the ads ever discuss policy or solutions to issues the country is facing. The ads often lack real facts or context to the facts they do include.
At the very least, if the parties are going to use attacks on each other as their tactics in these ads, I wish it wasn’t based on the most outlandish accusations. How can I trust either side when they both seem lowly and desperate to make others look bad instead of making themselves look good? I can’t imagine how these political commercials are actually convincing anyone of anything other than how flawed our political system is.
I think these advertisements open a bigger discussion about the media itself. Why are the ads so polarizing and negative? Why is it that the candidates play on your dislike or anger towards another candidate to make you vote for their side? Personally, as a consumer of these ads, I feel belittled and disrespected that these officials would try to sway my political views based on anger that lacks context. Why do they want the act of choosing who to vote for to come from a place of so much negativity?
These advertisements are not showcasing a better America-- they are representing the already corrupted and polarizing media tactics that many companies use to distract, manipulate and dehumanize consumers. Next time you see a political ad, ask yourself how this is intended to make you feel, and what is the candidate’s motivation for wanting me to feel that way?
OPINION POLICY
The goal of the Grand Valley Lanthorn’s opinion page is to act as a forum for public discussion, comment and criticism in the Grand Valley State University community. Student and columnist opinions published here do not necessarily reflect those of the paper as an entity.
The Lanthorn strives to be a safe vehicle for community discussion. With this in mind, the Lanthorn will not publish or entertain any forms of hate speech, but neither will it discriminate against any other views, opinions or beliefs.
The content, information and views expressed are not approved by-nor do they necessarily represent those of-the university or its Board of Trustees, officers, faculty or staff.
Letter to the editor should include the author’s full name, relevant title and a headshot, along with a valid email address and phone number for confirming the identity of the author. Letters should be approximately 500650 words in length, and they are not edited by the Lanthorn staff except to fix technical errors or to clarify. Reader submissions on the opinion page appear as space permits.
To make a submission, email editorial@ lanthorn.com or drop your submission off in person at:
0051 KIRKHOF CENTER
GRAND VALLEY STATE UNIVERSITY
ALLENDALE, MI 49401
616-826-8276

BY LANTHORN EDITORIAL BOARD LANTHORNEDITORIAL@GVSU.EDU
The COVID-19 pandemic not only changed the way we look at sickness in the United States, but physically mandated taking time to heal and recover (a move rarely seen in corporate, consumerist America). Now that case numbers have dropped and vaccines are available, the subject of sickness is at a crossroads– how are we expected to handle illnesses? Especially in college, it can be a struggle for students to stay home when they are not given the proper academic resources to do so.
Discussions range from continued COVID-19 testing to wearing masks when ill to attendance policies. Questions remain as to what social norms developed over the pandemic we should be keeping up with, and it seems our professors have the same issue.
Attendance policies across GVSU are vastly different, with some instructors being lenient and allowing for multiple excused absences, while others allow only one– excused or unexcused. These policies are often reflected in participation grades for a course, which can all too quickly tank
if a student’s absences go beyond the policy’s outline. This situation poses a struggle for students (us included) as they prioritize the difficult decision of whether to protect their health or their grades.
As cold and flu season begins, many students and faculty members are struggling with expectations of how to navigate illness. The majority of classrooms seem to be running without the anticipation of sickness or positive COVID-19 tests that can interrupt academics. Despite the lack of current discourse surrounding illness, we still find the subject to be prevalent. As of this past week, the Centers for Disease Control and Prevention (CDC) reported that 2.4% rate of deaths in Michigan are due to COVID-19. Here at the Lanthorn, we believe it’s important for GVSU to remember that health should always be your main priority.
It’s easy to get caught up in our day-to-day responsibilities like work, classes and homework. These responsibilities are still looming, despite the difficulty in completing these tasks when ill. This is why we think society should allow for more flexibility when it comes to school and work when someone is ill. An article
by American River Healthcare notes that resting can assist in recovery in a number of ways, including the minimization of stress present on a daily basis. The article says stress “can make even something as traditionally light as a cold worse,” and can “increase the negative perceptions of illness, so you also feel sicker.”
Let’s not forget that during the lockdown in 2020, we incorporated resources into our lives that allowed us to continue functioning from home when facing sicknesses. For GVSU, this included virtual meeting sites like Zoom and asynchronous online learning via Blackboard. While these resources aren’t needed on such a large basis anymore, we feel it is a waste to not acknowledge these resources’ availability. We still have the virtual capacity as a University to allow students to keep up with school work, and take the time needed to focus on their bodily health. Students shouldn’t forget about this just because we aren’t facing a lockdown.
In addition to this, we should also maintain the use and access to resources that help to prevent the spread of illness. During the height of the pandemic, it was essential to “mask up,” regularly wash and
disinfect your hands and be mindful of the spread of germs in close quarters. While these are practices we associate with COVID-19, they are generally effective measures to prevent the spread of sickness and disease.
The CDC states that proper hand hygiene can lower the risk of spread for respiratory diseases in the general population by 16-21%, making staying healthy (and remaining healthy) almost as easy as just washing your hands.
Post-pandemic, we feel that it’s more necessary now than ever to maintain self-care and compassion during times of sickness, despite the constant expectations in such a forward-racing work and academic world. There still needs to be grace for human needs. COVID-19, as well as other illnesses, still exist– even after the pandemic. We shouldn’t throw away the emphasis placed on health that was established through COVID-19, as well as the cognizance for the immunocompromised. We feel that as members of the GVSU community, we have a responsibility to be considerate to our fellow students and staff members. Students must do their best to maintain a healthy and safe environment for all individuals.


The School of Criminology, Criminal Justice and Legal Studies (CCJ) at Grand Valley State University hosted a“Courtroom Conversations” judicial panel on Wednesday, Oct. 2. The forum featured judges from the federal, state and local levels, allowing students to gain a better understanding of justicebased issues from experienced sources.
The event took place in GVSU’s Loosemore Auditorium at the Richard M. Devos Center in Downtown Grand Rapids. Students in attendance were able to engage with five judges working in Michigan courts at various levels, network with industry professionals and better understand the trials and tribulations of judiciary work.
The Criminal Justice Student’s Association (CJSA) and the National Criminal Justice Honor Society, Alpha Phi Sigma, assisted with planning and promotion for the forum, according to Patrick Gerkin, a professor within CCJ. Judges on the panel included Chief Judge Hala Jarbou of the U.S. District Court, Chief Judge Scott Dales of the U.S. Bankruptcy Court in the Western District of Michigan and Chief Probate Judge David M. Murkowski of the Kent County Probate Court. Other judges participating included Christopher P. Yates, a judge in the Michigan Court of Appeals for the 3rd District, and Patricia D. Gardner, a judge in the Family and Juvenile Court for the 17th Circuit Court of Michigan.
During the forum, three students sat on stage with the panel and pitched questions to the judges. The student panelists were CJSA President Melissa Jackson and Alpha Phi Sigma members Chloe Upton and Natalie Greenbauer. Jackson said planning the forum and participating in discussions was an exciting experience.
“I absolutely loved being a panelist,” Jackson said. “When the idea of this event was presented to me, I was very quick to jump on the planning for it.” Gerkin said the student turnout led to a successful, impactful event, and that from the initial pitch to the panel on Oct. 2, the forum took about a year in the making.
“The event was amazing,” Gerkin said. “We estimate that we had a student audience of approximately 115-120.
“You want to pass on that skill set that you developed. You want your employee and colleague to enjoy that skill set, and develop a skill set too.”

Students (could) learn firsthand what it takes to become a judge, as well as what it’s like to perform this essential work. Many of the students stayed around after the event and enjoyed the opportunity to extend the conversation with our panel of judges.”
The forum’s inspiration spurred from faculty’s conversations with judicial figures and the judges’ passion to share their experiences with students. Many of the panel members had previously been guest lecturers in various criminal justice classes at GVSU.
“The event was first pitched by one of our adjunct (faculty), Mike Ley, (who) is well connected with judges across West Michigan,” Gerkin said. “In his many conversations with judges, he noted that they shared a passion for talking with students and sharing their knowledge. After getting a positive response from the judges, Mike approached me and I said I would help him make it happen.”
Questions pitched to the judges covered a range of topics from experience, advice for students and technological innovations in the
courtroom. Each of the judges had an extensive educational background and have been involved in the court system for a long time. All of the panelists expressed that they wouldn’t be where they are if it weren’t for the mentors in their lives.
Dales said his relationship with his mentor was the reason he became a court judge. He shared that he never thought he’d be a judge, however his mentor saw something in him that inspired his professional career.
“Mentors are terribly important,”
Dales said. “If you can find a mentor, find a mentor. It took somebody that I trusted to see something in me (that) I didn’t really see in myself. (That’s what) brought me to apply (to be a judge).”
Murkowski has been the chief probate judge for the Kent County Probate Court for 17 years. Murkowski described his transition from being mentored to now being a mentor himself.
“(Being a mentor is) most fulfilling and it’s most rewarding,” Murkowski said. “You want to pass on that skill
set that you developed. You want your employee and colleague to enjoy that skill set, and develop a skill set too.”
Murkowski and other judges encouraged students to sit in on court sessions and learn about the judicial process as early on in their studies as they can. The panel of judges recommended that students continue to increase their knowledge upon entering the workforce by discussing cases with other lawyers and judges, and seeking out educational opportunities.
“From a student perspective, this event was a great networking opportunity to connect with judges and get their perspective on what their process looked like for becoming a judge, (and) their insight on the questions that we had curated,” said Jackson. “Other students who attended (also) commented on how it was a great opportunity to hear (responses) from a judge’s perspective, while also being able to connect with them afterward.”


BY LEE MARENTETTE LANTHORNEDITORIAL@GVSU.EDU
The annual Shakespeare Festival hosted by Grand Valley State University’s Department of Music, Theatre and Dance (MTD) kicked off on Oct. 4 with the GVSU Theatre’s opening performance of “Romeo and Juliet.”
“Romeo and Juliet” is the Shakespearean classic in which Romeo, a Montague, and Juliet, a Capulet, fall in love in the midst of a longstanding family feud. The GVSU adaption sets the play in the 1930s to display a greater contrast, with the Montagues implied to be a Sicilian mafia family and the Capulets to be Italian fascists.
“I think what I was really interested in was creating a world where the Capulets and the Montagues were easily distinguishable,” said Patrick Poole, the show’s guest director.
The play showcases this by changing the costumes from traditional Renaissance clothing to the suits and military uniforms of 1930s Italy.
“Many times, you see colors (to distinguish the families), but more,

some of the ideas or organizations that they represent,” Poole said.
For the students and actors involved, many were relatively new to Shakespeare and the famous production, which

caused some cast members to feel intimidated. Evan Bolla noted that playing Romeo has been the biggest role yet of his acting career.
“It was the biggest shock to the system (that) I’ve ever had in my eight years of theater,” Bolla said. “I knew it was going to be a big undertaking, especially considering I’m still very new to the theater system at Grand Valley, but I was willing to take on this big role.”
Molly Fenn, who plays Juliet Capulet, said that for many in GVSU Theatre, the play is the first time performing a Shakespearean classic.
“Coming into the show, with it being one of the most famous Shakespeare plays, was really nerveracking,” Fenn said. “The majority of us weren’t very knowledgeable when it came to Shakespeare (and) we had only really done one or two shows (prior).”
The old English language of Shakespearean plays can be one of the biggest challenges for actors involved. To help with this, Poole took extra time to ensure that his cast fully understood the play and its language.
“The clarity comes from the cast,” Poole said. “It’s the work that they’ve done in our (table reads) and in our scene work that has led to confidence. This will be a clear story for people to follow, even if they’re not extremely familiar with (the dialogue).”
Poole’s work with the cast, along
with the modern framing of the adaption, was done in hopes that the play is easier for the audience to understand and enjoy. The attention to detail also put many of the cast members at ease and allowed them to appreciate the play to its fullest extent.
“It feels extra rewarding when you come home from a rehearsal knowing you’ve gained new knowledge about something you didn’t know before,” Fenn said. “I’m honestly grateful we took the time to slowly move through and really truly understand what was going on, what (their characters) were saying and what every single line meant. It makes you appreciate Shakespeare for what it really is.”
Both Fenn and Bolla are excited to perform “Romeo and Juliet” again from Oct. 10-13 and continue their work with GVSU Theatre.
The Grand Valley Shakespeare Festival is Michigan’s oldest and largest Shakespeare festival. The festival is hosted yearly by GVSU Theatre and includes workshops, an art competition, an on-campus Renaissance Festival and a mainstage performance. The festival will go on a tour of secondary schools with a separate, shorter performance of Shakespeare’s “Bard to Go,” before stopping back at GVSU for a final production of the shorter performance on Oct. 26.

BY LACIE HOFFMAN
Woodstock Fest, a benefit concert held in Grand Rapids on Oct. 5, supported the ElMassry-Sahmound family’s survival in Gaza, as well as local artists and musicians. The festival, which was held at Heritage Hill, was co-organized by Grand Valley State University Professor James Champion, and is held annually in an effort to garner exposure and donations to specific causes.
This year, Woodstock Fest partnered with Palestine Solidarity Grand Rapids, a political organization that organizes in the Grand Rapids area for the liberation of Palestine. Partnering with Woodstock allowed the organization to help raise donations for the ElMassry-Sahmound family, which is trying to escape devastation in Gaza and relocate to Egypt. The money sent to the family in need will be used for supplies including food, water and sanitary items until they are able to evacuate from Gaza.
The festival featured 14 local artists, including GVSU student Anthony Erlandson. Performers played a variety of musical genres including folk, hyper pop, punk and more.

Additionally, this year the festival featured a costume party, and ended the night with a bonfire for guests to relax and enjoy.
Champion helped found the volunteer-based festival in 2018. The event gives local community members interested in the arts an opportunity to get involved and help uplift surrounding communities.
“(It’s exciting) to hang out with all the volunteers (at the festival) because normally, we are in serious meeting mode,” Champion said. “We are all goofy people, but it (is) fun to not be

talking about the event and just be at it.”
In past years, the festival has focused on raising money to support LGBTQ+ community members, but this year, it was decided that it was more pertinent to donate to the Palestinian community.
“It is emotionally impactful for us to do and to be able to do it together,” Champion said. “(So), raising money for a global concern is what we decided to do this year.”
The festival runs on a volunteer basis, with individuals donating their time, money and talents to help make the event a success. Champion added
that he hopes those in attendance at the festival and others who donated were supplied with a little bit of hope.
Many of Woodstock’s performing artists agreed to donate a portion of their merchandise sales to the ElMassry-Sahmound family.
In addition to donating to the ElMassrySahmound family, festivalgoers had the opportunity to donate to Woodstock Fest’s continuation in the years to come.
“If we (were) going to raise money, (the festival) had to be big,” Champion said. “It was really beautiful and inspiring because people showed up.”


BY ABBIE SUAREZ LANTHORNEDITORAL@GVSU.EDU
Grand Valley State University’s chapter of Public Relations Student Society of America (GV PRSSA) hosted an agency tour on Friday, Sept. 27. The tour offered students an invaluable glimpse into the dynamic field of PR by providing realworld insights into the strategies that shape corporate and public communications.
Throughout the year, GV PRSSA coordinates multiple agency tours in various locations, including Detroit, Lansing, Kalamazoo and Chicago. These excursions are designed to give students a panoramic view of the PR landscape by visiting both in-house communications departments and PR agencies, thereby covering a wide spectrum of professional experiences.
The group’s September tour, held in Grand Rapids, involved visits to both the City of Grand Rapids’ Communications Department and the Van Andel Arena-two entities where public relations play a crucial role in operating on a day-today basis. For the GV PRSSA members, the visits were not just about observing; they were about understanding how theory translates into practice, and how strategic communication drives engagement in business and governance.
While at the City of Grand Rapids’ Communications Department, students met with Andrea Riley Mukavetz, the City’s community engagement manager, and JD Waldvogel, the strategic marketing communications specialist. Both speakers shared how their work intertwines with public policy and community outreach. They both emphasized the importance of tailoring messages and campaigns to effectively connect with Grand Rapids’ diverse population.
Mukavetz and Waldvogel underscored how their individual backgrounds and interests shape their approach to creating communication strategies, offering students a multifaceted view of public sector PR.
The tour continued at Van Andel Arena, a key event and entertainment venue in downtown Grand Rapids, where Hannah Flynn, a former PRSSA member from Northern Michigan University provided a comprehensive overview of her role as communications coordinator. Flynn elaborated on her responsibilities in content creation and brand management, explaining how she navigates the intricacies of
Tours like this expose members to the various career paths available and allow them to ask questions and network directly with professionals.”
storytelling to maintain the venue’s cohesive image and public appeal.
Students were given a tour of the facilities, and Flynn discussed the unique challenges of working in an environment where each event brings a new audience, necessitating fresh content and strategic adaptability.
Junior Lauren Brasher serves as GV PRSSA’s vice president of professional development. Brasher, who played a role in planning the tour, emphasized the tour’s impact on students’ career outlooks.
“Overall, it was an amazing learning experience for us all, Brasher said. “I think a lot of our members were opened up to the career possibilities that an advertising/public relations major can achieve. Tours like this expose members to the various career paths available and allow them to ask questions and network directly with professionals.”
These experiences are supplements to the classroom instruction that forms the bedrock of students’ education in public relations. While academic courses cover essential PR strategies, they often fall short of exposing students to the day-today realities and diverse opportunities within the field. The GV PRSSA agency tours serve to bridge this gap, enabling members to witness firsthand the breadth of PR work across different industries and professional settings.
The chapter’s next tour is set for October 18 in Lansing, with planned visits to Piper & Gold and Martin Waymire, two notable public relations agencies.
GV PRSSA President Alexia Frazzitta, a GVSU senior, expressed enthusiasm about the upcoming tour, emphasizing its potential to provide a deeper understanding of agency life, which often differs significantly from in-house PR roles.
“Our agency tours allow members to network with PR professionals and learn more about an industry they may be interested in pursuing,” Frazzitta said. “Students come prepared with questions and often ask for advice on how to advance their professional career journey.”
The chapter’s dedication to providing practical experiences reflects its broader mission to prepare students for
successful careers in the public relations and communications industries.
GV PRSSA, which was established in 1977, is part of the nationwide Public Relations Student Society of America, an organization that connects over 7,000 students and advisors across more than 300 chapters. Often recognized as the premier student organization in the PR field, PRSSA aims to advance the practice and profession of public relations by offering its members extensive opportunities for networking, professional development and education.
The chapter also supports GrandPR, its student-run integrated communications firm. GrandPR
provides members with handson experience in managing client communications and developing PR campaigns.
For Brasher, whose specialty lies in writing and social media, GV PRSSA represents an opportunity to actively explore various facets of public relations and develop a clearer sense of the career she wishes to pursue.
“My dream job is to work somewhere that allows me to be constantly doing something new,” Brasher said, emphasizing the chapter’s role in helping her, and many others, discover their passion within the field.


BY BRADY KEMMERLING LANTHORNEDITORIAL@GVSU.EDU
The No. 2 ranked Grand Valley State University football team (5-0) kicked off conference play, traveling to nearby Davenport University (3-2) on Saturday, Oct. 5. The Lakers once again relied on their powerful rushing offense and run defense to secure them the win 24-7.
Heading into the matchup, the Lakers’ rush offense ranked third in the country, while also boasting the second-ranked rush defense.
Head coach Scott Wooster, a former collegiate offensive lineman himself, expressed the importance of controlling the run game on either side of the ball.
“Dominating the line of scrimmage is very important to us,” Wooster said. “We are seeing the right to rush the passer on defense, and we are creating a balance on offense with a powerful run game that opens up passing.”
Sophomore lineman Jaylin Caldwell added that maintaining dominance “breaks the spirit” of the opposing team.
“If you set up the run, it builds the foundation of who will dominate the game,” Caldwell said. “Our offensive line is working hard, and that makes everyone else work hard. The big guys up front push each other to be the best.”
Davenport opened up the game with a run of 32 yards, but following a sack by senior defensive tackle Jack Gilchrist and a couple of incomplete passes, the Panthers would turn the ball over on downs. The Lakers responded by handing the ball off to sophomore running back Khalil
Eichelberger, who pushed the Lakers into the red zone with a 52-yard run. However, the Panther’s defense held Grand Valley short of the goal line, resulting in a 22-yard field goal by senior kicker Kollin Kralapp.
GVSU’s defense would hold up the following drive with an endzone interception by junior cornerback Terez Reid.
In all five games the Lakers have played this season, they have scored on every opening drive, while not allowing any first quarter points. GVSU has outscored opponents in the first quarter 52-0 through five games.
A swing pass to redshirt freshman Kenneth Jones for 25 yards would set up the Lakers in the red zone to start the second quarter. Jones would immediately follow that up with a 27-yard rushing touchdown, putting the Lakers up 10-0.
After a three-and-out by Davenport, senior quarterback Avery Moore would find junior wide receiver Jordon Johnson deep for 45 yards. Shortly after, Moore was able to connect with Eichelberger in the flats for a quick 5-yard touchdown pass.
Davenport went on to string together an offensive drive, marching 66 yards down the field and scoring points of their own. The Lakers responded with an 89-yard drive, which ended similarly to their previous drive with a touchdown pass in the flats from Moore to Eichelberger.
Leading 24-7 at the half, GVSU received the kickoff heading into the third quarter. Although two more quarters of football were set to be played, neither team was able to find their way into the endzone. Repeated punts and turnover on downs persisted throughout

the remaining minutes of the game.
With little to be shown score-wise in the second half, the team’s offense was still productive.
“The first half was dominant offensively, and we can’t have much of a better start,” said Wooster. “We threw better today and created a balance with the run game. Although the score doesn’t show it, (we) were able to move the football in the second half. We just failed to reach the endzone. We gave up some yards in the first half, but our second-half adjustments on defense made us dominate. We are still searching for that complete football game. We have had these moments of dominance, but
nothing competes. We are a long way away from what we can be.”
Although the Lakers allowed more rushing yards than in this season’s past games, the defense was still confident in their ability to shut down opposing rushers.
“Stopping the run is what we pride ourselves on,” said Gilchrist. “We didn’t execute early in the game, but we came out with some adjustments and stopped the run well that second half. We will continue to practice hard and do what we know how to do.”
The Lakers will return home to Lubbers Stadium for their military appreciation game, and face off against Northern Michigan University (0-5) on Saturday, Oct. 12.


BY TORI BYRNE LANTHORNEDITORIAL@GVSU.EDU
Grand Valley State University’s volleyball team swept Roosevelt University in three sets, adding a fifth game to their winning streak.
Heading into Saturday’s match against the Roosevelt Lakers, Grand Valley led in the Great Lakes Intercollegiate Athletic Conference (GLIAC) with an overall record of 12-1 and a conference record of 5-1.
As a first-year member of the GLIAC, Roosevelt’s overall record is 1-12 with a conference record of 0-5.
Entering the match, GVSU’s dominant record and ranking were based on consistency. Facing teams such as Roosevelt test the Lakers’ motivation and grit from all levels of competition. Head coach Jason Johnson stressed the importance of consistency and how it motivates the team to prepare for tougher matches.
“The level of competition always is going to play into the energy that you’re bringing into the gym, but we try to push our players to be very consistent with the type of energy and
preparation that they have heading into any match, regardless of who it is or what the perceived level of competition might be,” said Johnson.
Maintaining consistency relies on what athletes do on and off the court. Creating a routine and habits can set a foundation for success. Senior Julia Blaney stressed the importance of her pregame routine to keep her motivated and consistent.
“I go by myself and I do a prayer, a worship song and then I watch a motivational video,” Blaney said. “I visualize and then I meet with the team to have our dance party (before the game).”
Translating the individual and team routines into gameplay is exactly what the Lakers do best.
The Lakers started their first set against Roosevelt strongly with an early lead of 11-0. Disrupting GVSU’s lead with an attack error by junior Kendall Stover, Roosevelt was allowed to put their first point on the board. However, the Lakers persevered and continued to use their momentum to gain crucial points. They increased their lead up to 15-1 after a major kill from sophomore Kennedy Arp. The Lakers then cruised on to 20 points

with 2 kills from sophomore Kate Goudreau and 2 service aces for junior Meghan O’Sullivan. From there, the team secured the opening set win, 25-8.
Starting the second set, Roosevelt stayed level with GVSU but never took the lead. At 12-7, the momentum changed for GVSU due to a major kill from Arp.
The Lakers took advantage of Roosevelt’s attack errors and ran with the lead at 17-9.

Ending the set on a 10-4 run, the Lakers secured the second set at 25-11.
In the final set, GVSU led 7-0 from Roosevelt’s attacking errors and a kill by Gourdreau. Roosevelt dug deep for momentum and trailed the Lakers 7-10. The Lakers gained a 4-point run and Roosevelt responded with a 5-point run, taking the set to 14-11. Redshirt sophomore Brianna Stawski provided two crucial points with massive kills that helped GVSU bring the score to 17-12. Roosevelt grew into the game and continued to put up points, but could never get closer than three points. GVSU closed out the third set with a perfect setup from O’Sullivan for Stover to put it away, ending the set 25-16.
GVSU’s game leaders offensively were Stawski, with nine kills on a .750 hitting percentage, Goudreau with six kills on a .857 hitting percentage and Arp with five kills on a .714 hitting percentage. The defensive leaders were O’Sullivan with five kills and 17 assists, Blaney with 14 digs and Caroline Baker with 12 assists.
Defeating Roosevelt in a 3-set sweep added to GVSU’s winning streak and hunger for more wins. Reflecting on the game, Stawski shared her training focus for the next match.
“I like to go early on a lot of attacking, so patience and keeping my hands up (is important),” Stawski said. “I’d say consistency in a lot of those areas (is my focus).”
For their next competition, the Lakers will travel to Kenosha, Wisconsin to face off against the Parkside Rangers on Friday, Oct. 11.

BY ETHAN OUTMAN LANTHORNEDITORIAL@GVSU.EDU
The Grand Valley State University’s men’s and women’s cross country teams competed in the Joe Piane Notre Dame Invitational, which saw over 25 Lakers earn their personal bests.
Oct 4. marked the first time GVSU’s cross country teams have attended Notre Dame’s invitational in over a decade. The teams ran in four of the six races-- the Women’s Blue 5k, the Men’s Blue 8k, the Women’s Open 5k and the Men’s Open 8k. The teams saw success in all four of these races.
Of the nine total Lakers who ran in the Women’s Blue 5k, each of them finished with a personal record, with senior Abby Olson placing first for the women’s team. Olson finished with a time of 16:59.2, landing in forty-ninth place of 191 racers.
The Lakers saw similar success in the Men’s Blue 8k. The top five racers for GVSU all earned personal bests. Leading the pack was senior Caleb Futter who placed seventeenth out of 166 runners. He finished the race with 22:58.6 as his new record.
Building off their first two races, all four of Grand Valley’s racers in the Women’s Open 5k earned their personal records. The top finisher for the Lakers in this race was junior Madison Ebright with a time of 17:57.8. Having four women all run their best times meant that every single runner from the GVSU women’s cross country team earned a PR at the invitational.
The men followed this up with all seven of GVSU’s racers earning their personal records in the Men’s Open 8k. Senior Patrick Lyell led the Lakers in this race, with a time of 24:21.1. The impressive run earned him twenty-second place.
Among the racers who achieved their personal bests was redshirt junior Colin Hanson, who shared the mentality needed to earn a PR.
“I just try to make sure my mind is in a calm place, so I’ll listen to some chill music,” said Hanson. “I just remind myself that all the hard work is done at that point, I just have to be mentally ready to put it together in the race.”
Hanson admitted to having some nervousness right before the race.
“The pre-race nerves are always going to be there, but you learn to use that as an advantage rather than a detriment,” Hanson said. “You have to acknowledge that it’s going to hurt pretty bad at some point in the race, and just be mentally ready to embrace that.”
Although Hanson was able to maintain this mindset and achieve a PR of 25:10.0 in the Men’s Open 8k, he took little time to revel in his success, and remains focused on the future.
“(I) just enjoy it for a little bit, and move onto the next race,” said Hanson.”Really, the end goal is preparing for nationals and seeing how good we can be both individually and as a team.”
The teams hope to build onto their momentum when they compete in the Lewis Crossover Invite in Romeoville, Illinois and the Muskegon Jayhawk Invite, both on Saturday, Oct. 12.





“I’ve done my research, and I’ve made my choice. Your research is all yours to do, and the choice is yours to make. I also want to say, especially to first time voters: Remember that in order to vote, you have to be registered! I also find it’s much easier to vote early.”
- Taylor Swift
Online + Mail Registration Deadline in MI: October 21, 2024
In-Person Registration Deadline: November 5, 2024
Election Day: November 5, 2024
